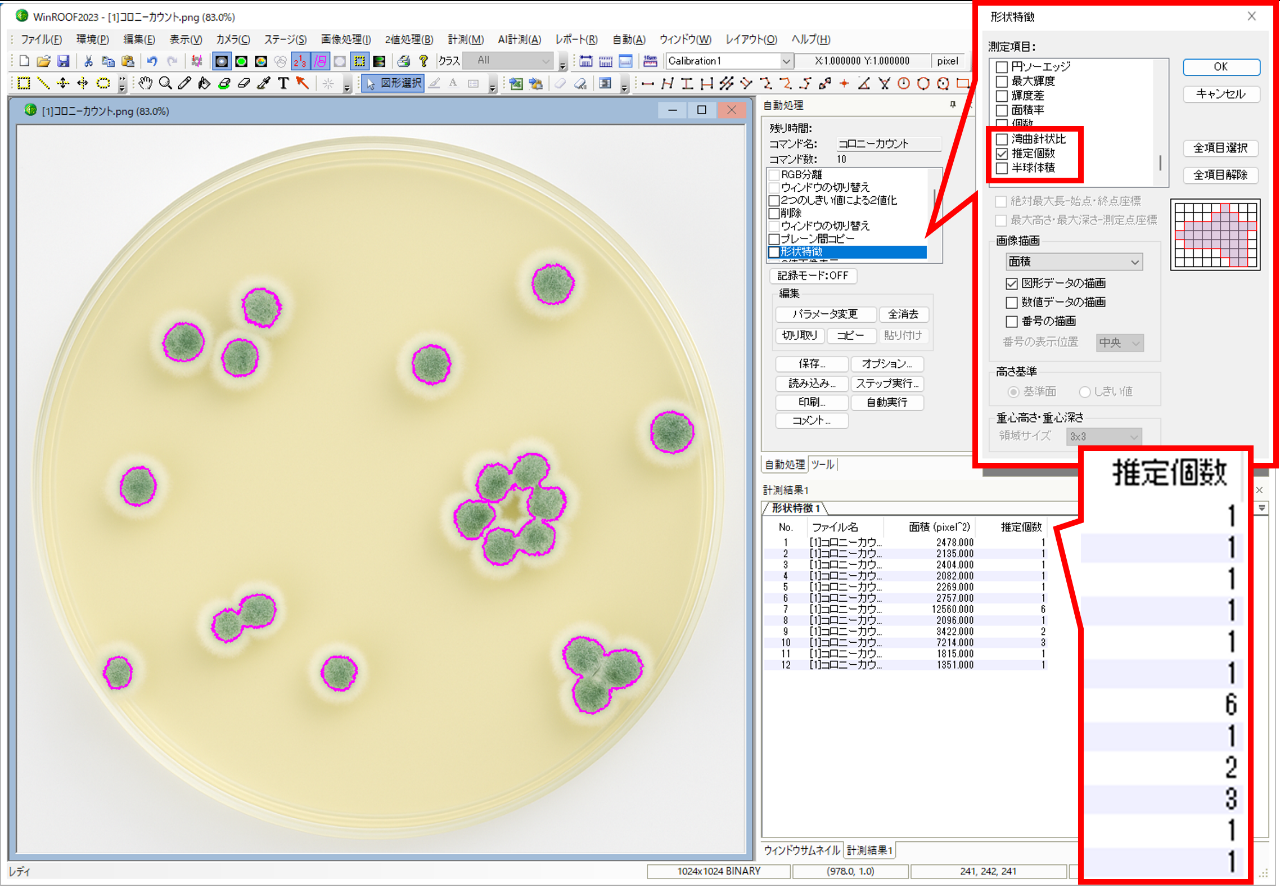
任測定項目

ソフトウエア
画像処理ソフトウェアWinROOFシリーズ - 任意測定項目
今回は2025年のバージョンアップにより、WinROOFへ加わった便利な機能『任意測定項目』機能をご紹介します。
過去に、画像解析ソフトや顕微鏡/SEM用ソフト、あるいはフリーソフトを使ってみたものの、「思ったような結果が出ない...」と頭を抱えた経験はありませんか?
「画像解析ソフトだけでは直接結果が求められず、Excelなどで再計算する手間がかかる」
「顕微鏡/SEMの基本機能では測定できない」
「フリーソフトでは、どの項目で計算できるか分からない」
というユーザーの皆様のお声から、オリジナルの測定項目を作成することができる『任意測定項目』機能が誕生しました。
「ユーザーの皆様が、測定項目を作成することができる」というのは、どういうことなのか。さっそく、作成例をご紹介します!
オリジナルの測定項目を作成しよう
たとえば、寒天培地に生えたカビのコロニーの画像。
それぞれ、いくつのコロニーが連なっているのかカウントしてみます。

①名前を付ける
作成するオリジナルの測定項目に名前を付けます。
今回は「推定個数」とします。
②単位を選択する
結果出力時の単位を選択します。
mmやpixelなどが選択できますが、今回は個数のカウントのため、単位は付けません。
③計算式を作る
円形度や面積といった測定項目に、数字や足し算・割り算を組み合わせて、オリジナルの計算式を作ることができます。
組み合わせ可能な測定項目は100種類以上用意されており、目的に応じて自由に選択可能です。
さらに、最大値や最小値、平均値などの統計値も使えるので、より実践的な解析が行えます。
今回は連なっているコロニーの数をカウントしたいので、ひとかたまりの面積から
コロニー1個あたりの面積(約2100pixel)を割ることで、推定の個数を測定します。
推定個数=コロニーの面積(pixel) ÷ 連なっていない1コロニーあたりの面積(pixel)
④登録する
[登録]ボタンを押すことで、登録が完了し、測定項目一覧に表示されます。登録したオリジナルの測定項目は実際に測定することも可能ですし、検出した粒子の場合分け(削除)にもご利用可能です。
作成した測定項目を使用して計測しよう
測定項目を作成したら、コロニーを検出して、測定を行います。
WinROOFでの検出方法が気になる方は、こちらの記事をご覧ください!
■■WinROOF操作例 - 2値化を使った初歩的な測定|MiVLog(ミブログ)■■
■■画像処理ソフトウェアWinROOFの最新機能「スマート抽出」を試してみた。|MiVLog(ミブログ)■■

検出した領域は、既存の測定項目や作成した「任意測定項目」から選んで計測することができます。一度、マクロに登録すれば、自動で計測することが可能です。
WinROOFでの自動処理マクロの作成方法が気になる方は、こちらの記事をご覧ください!
■■WinROOF操作例-マクロを使った自動処理|MiVLog(ミブログ)■■
■■ImageJでの初歩的なマクロの作り方 ~画像処理を自動化しよう~|MiVLog(ミブログ)■■
WinROOFシリーズの特徴
いかがでしたか。WinROOFにはその他にも便利な機能が多数あり、顕微鏡、デジタルカメラ、スマートフォンなどで撮影した画像を解析することができます。複数枚の画像を一気に解析したり、解析結果をExcelやCSVへレポート出力したりすることも可能です。
WinROOFをはじめとした弊社ソフトウェアは、ユーザーの皆様方のご要望を反映し、便利な新機能を加えて日々進化を続けております。画像解析に課題をお持ちの方、WinROOFシリーズ、その他の弊社ソフトウェアにご興味がある方、お気軽にお問い合わせください!
三谷商事ビジュアルシステム部 問い合わせフォーム
■■三谷商事ビジュアルシステム部への問い合わせはこちらをクリック!■■










